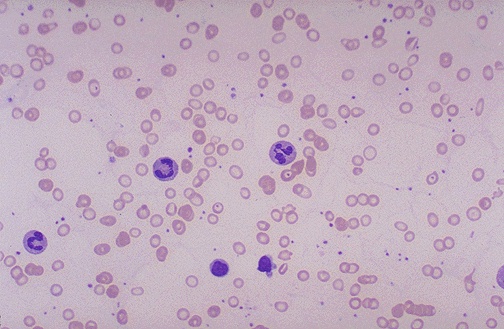

| The RBC's here appear smaller than normal and have an increased zone of central pallor. This is indicative of a hypochromic (less hemoglobin in each RBC) and microcytic (smaller size of each RBC) anemia. There is also increased anisocytosis (variation in RBC size) and poikilocytosis (variation in RBC shape). |
![]() |